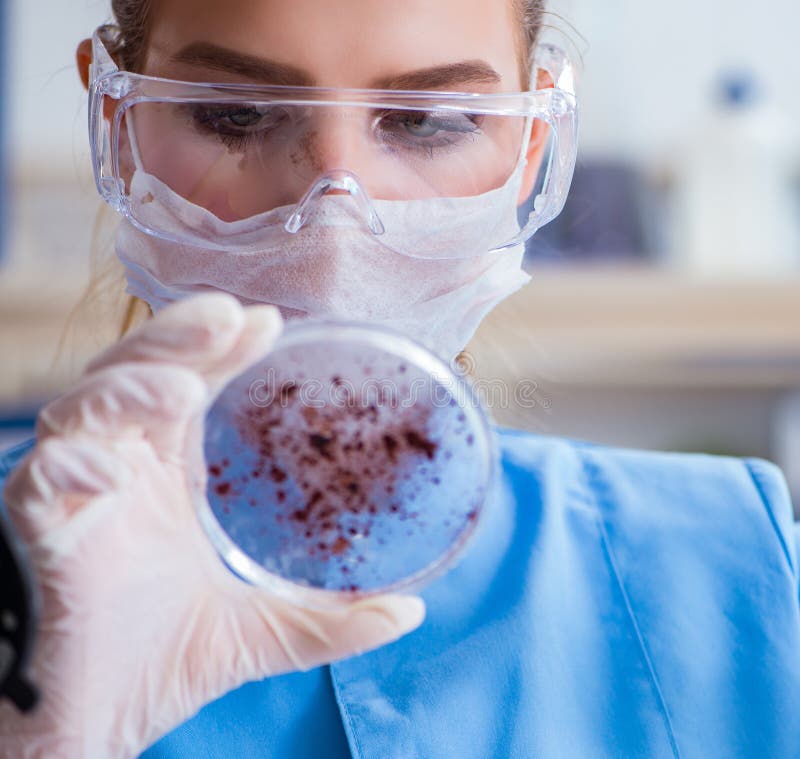

Libera da Diritti Foto stock

Ricercatore femminile dello scienziato che esegue un esperimento in un laboratorio
- ?
Dimensione MAX
6016x4016px •
20.1" x 13.4" • @300dpi •
5.7MB • jpg
Linea di accreditamento autore
Parole chiave immagine
Più immagini stock simili
















































































Altre immagini con questo modello